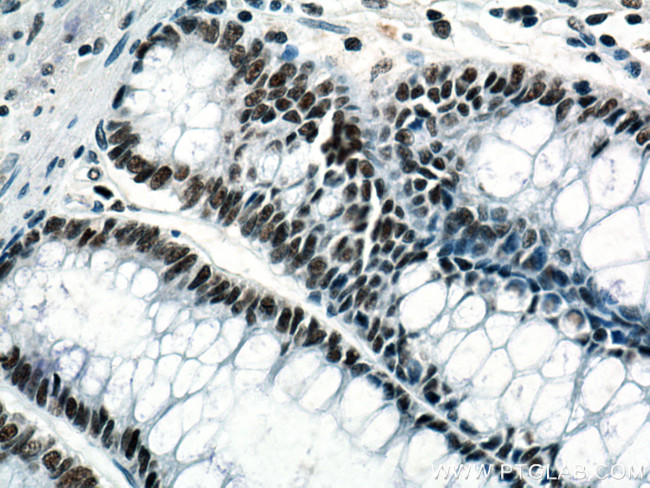
KDM1 Antibody in Immunohistochemistry (Paraffin) (IHC (P))

Search
Proteintech
KDM1 Monoclonal Antibody (2F10A12)
{{$productOrderCtrl.translations['antibody.pdp.commerceCard.promotion.promotions']}}
{{$productOrderCtrl.translations['antibody.pdp.commerceCard.promotion.viewpromo']}}
{{$productOrderCtrl.translations['antibody.pdp.commerceCard.promotion.promocode']}}: {{promo.promoCode}} {{promo.promoTitle}} {{promo.promoDescription}}. {{$productOrderCtrl.translations['antibody.pdp.commerceCard.promotion.learnmore']}}
产品信息
67037-1-IG
种属反应
宿主/亚型
分类
类型
克隆号
抗原
偶联物
形式
浓度
规格
纯化类型
保存液
内含物
保存条件
运输条件
产品详细信息
Aliquoting is unnecessary for -20°C storage.
靶标信息
LSD1 is a histone demethylase that specifically demethylates 'Lys-4' of histone H3, a specific tag for epigenetic transcriptional activation, thereby acting as a corepressor. LSD1 contains a SWIRM domain, a FAD-binding motif, and an amine oxidase domain. This protein is a component of several histone deacetylase complexes, though it silences genes by functioning as a histone demethylase. It acts by oxidizing the substrate by FAD to generate the corresponding imine that is subsequently hydrolyzed. LSD1 demethylates both mono- and tri-methylted 'Lys-4' of histone H3. This protein may play a role in the repression of neuronal genes. Alone, it is unable to demethylate H3 'Lys-4' on nucleosomes and requires the presence of RCOR1/CoREST to achieve such activity. It may also demethylate 'Lys-9' of histone H3, a specific tag for epigenetic transcriptional repression, thereby leading to derepression of androgen receptor target genes. Mutations affecting this gene can result in cleft palate, psychomotor retardation, and distintive facial features.
仅用于科研。不用于诊断过程。未经明确授权不得转售。
生物信息学
蛋白别名: [histone H3]-dimethyl-L-lysine(4) FAD-dependent demethylase 1A; amine oxidase (flavin containing) domain 2; BRAF35-HDAC complex protein BHC110; F9F13.30; F9F13_30; FAD-binding protein BRAF35-HDAC complex, 110 kDa subunit; Flavin-containing amine oxidase domain-containing protein 2; Flavin-containingso amine oxidase domain-containing protein 2; LESION SIMULATING DISEASE; LESION SIMULATING DISEASE 1; lysine (K)-specific demethylase 1; lysine (K)-specific demethylase 1A; lysine-specific histone demethylase 1; Lysine-specific histone demethylase 1A; neuroprotective protein 3; RP1-184J9.1; unnamed protein product
基因别名: 1810043O07Rik; AA408884; AIMAH3; AOF2; BHC110; CPRF; D4Ertd478e; KDM1; KDM1A; KIAA0601; LSD1; mKIAA0601; RGD1562975
UniProt ID: (Human) Q96AW4, (Mouse) Q6ZQ88, (Rat) A0A8I6G2K8
Entrez Gene ID: (Human) 23028, (Mouse) 99982, (Rat) 500569